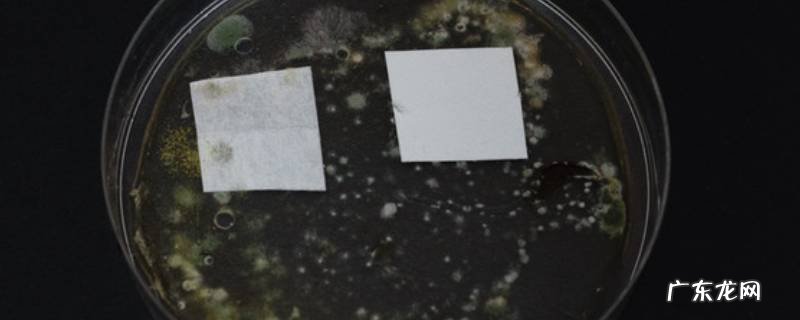

文章插图
清理橡胶圈上的霉斑所需材料有红米、大米,共分为四个步骤,以下是清理橡胶圈上霉斑的详细操作:
操作/步骤
1
用小苏打洗
将其和水混合来回擦拭橡胶圈即可 。
【饭盒盖子橡胶圈黑色霉斑怎么清理 饭盒密封圈黑斑洗不掉】2
用洗洁精洗
将洗洁精滴在饭盒上的橡胶圈上,用布来回擦拭即可 。
3
用食用碱洗
用适量的食用碱加水稀释,倒在橡胶圈上进行刷洗即可 。
4
用土豆泥洗
土豆捣成糊状抹在橡胶圈上有黑点的位置,刷洗干净即可 。
END
总结:以上就是关于饭盒盖子橡胶圈黑色霉斑怎么清理的具体操作步骤,希望对大家有帮助 。
- 泡面盒子能放入微波炉加热,方便面送的塑料饭盒能用微波炉加热
- 饭盒盖子上霉怎么去除,饭盒密封圈上的霉斑怎么去除
- 什么饭盒可以在微波炉加热,什么盒子可以放进微波炉
- 过度浇水 冬天养护橡皮树的禁忌有哪些
- 洗饭盒方法 洗饭盒方法简述,塑料饭盒用久了怎么清洗的透明干净
- 硅橡胶的特性及用途,谁知道硅胶具体有哪些特点和用途
- 泡沫盒子能进微波炉,泡沫饭盒能放微波炉加热危害
- 牛筋底是什么材料,牛筋底好还是橡胶底好
- 微波炉热菜用什么器皿,微波炉热饭的饭盒要什么材质的比较好
- pvc鞋底是软还是硬,pvc和橡胶底哪个舒服防滑
特别声明:本站内容均来自网友提供或互联网,仅供参考,请勿用于商业和其他非法用途。如果侵犯了您的权益请与我们联系,我们将在24小时内删除。
